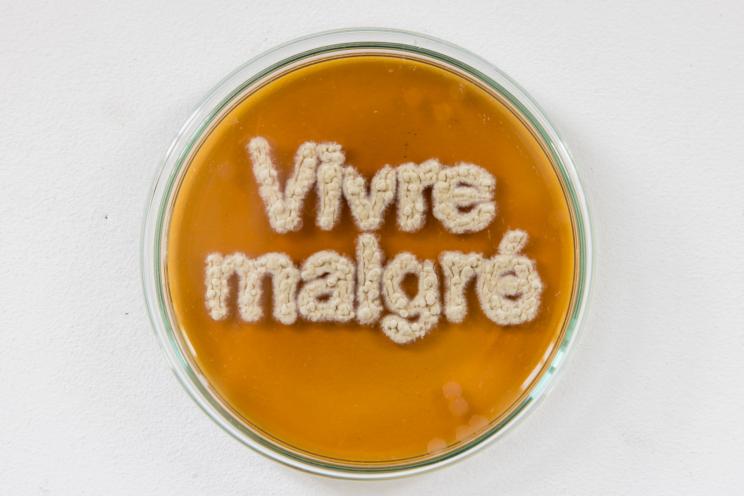

-
 AE F.Pliskin ©Amelie Canon
AE F.Pliskin ©Amelie Canon -

-

-
-

-

-

-
AFTER Project Room #1 De rire sur les cendres
Du 11 au 27 octobre 2024
Vernissage le 9 octobre, 18h
21 rue de Turenne, 75004 Paris -
AFTER Project Room #2 Un château de sable sous la paupière
Du 8 au 24 novembre 2024
Vernissage le 6 novembre à 18h
21 boulevard des Capucines
75002 Paris -
AFTER 2024
Du 6 au 15 décembre 2024
Tour Orion, Montreuil -

-

AFTER, l’APRES ÉCOLE
Afin de leur donner toutes les chances de s’insérer dans le monde professionnel en les mettant en contact avec les entreprises soucieuses de leur impact pour les générations futures, l’École lance en 2024 un ambitieux programme tremplin nommé « AFTER ». 3 dispositifs inédits de révélation des générations sortantes de l’Ecole des Arts Décoratifs. Chaque dispositif est construit selon une stratégie complémentaire au dispositif global, afin de guider ces jeunes professionnels vers leur devenir.
DEUX PROJECTS ROOMS
À l’occasion des mois de l’art contemporain et de la photo à Paris, AFTER se fait espace immersif en activant deux lieux inédits des quartiers du marais et de l’Opéra Garnier par l’exposition d’une vingtaine de jeunes diplômé.es 2024. Nouvelle garde des arts écologiques et politiques, désormais apte à reconfigurer concrètement nos milieux de vie, à la fois réels et imaginaires, visuels et matériels, analogiques et digitaux, naturels et artificiels, l’École du décor actif fait battre le pouls artistique de la capitale.
Avide de bousculer et de reformuler l’héritage des générations passées, la jeunesse créative est saisie grâce à AFTER au moment vif et urgent de sa bascule vers l’après École. Ses visions, ses formalisations, ses engagements, sont autant de faisceaux tangibles d’une école en prise avec les défis de l’époque, reformulés chaque année par celle.eux qui la font.
Afin de maximaliser les potentialités de rencontre entre les artistes et le public, la direction artistique des deux Project Rooms a été confiée à Noémie Vidé, diplômée de l’école, fondatrice de Bureau Communes en collaboration avec Pauline Hutin, elle-même diplômée 2024 en scénographie. Une conjugaison des échelles, de l'espace à l'objet, pour une fabrique de l’utile et du beau ouverte à tou.tes.
AFTER 2024, l’EXPOSITION
Après deux Project Rooms dédiés à l’art contemporain et à l’image photo/vidéo, AFTER se fait exposition d’ampleur en présentant une cinquantaine de diplômé.es issu.es des dix secteurs de formation de l’École des Arts Décoratifs – PSL. Le commissariat d’exposition est assuré par Anna Labouze & Keimis Henni, la scénographie est confié au studio BigTime.
Avec le soutien d’Alios Développement.
UNE PREMIERE EDITION, AFTER 2023
Cette édition rassemble les projets de diplômes et de thèse présentés par les étudiant·es à la fin de leur cursus, juste avant qu’ils et elles ne quittent l’école et pénètrent dans le monde, riches de savoirs acquis, de formes produites et d’expériences vécues. La direction artistique est chaque année confiée à un.e diplômé.e en Design graphique. Pour After2023, c’est Aletheïa qui met en valeur ces diplômes de master, post-masters et groupes de recherches.
Fondation Gecina, partenaire d’AFTER
Avec le soutien de la Fondation Gecina, mécène de l’École des Arts Décoratifs – PSL.
Communiqué de presse
| Télécharger le communiqué | Document PDF | Visualiser | Télécharger |











